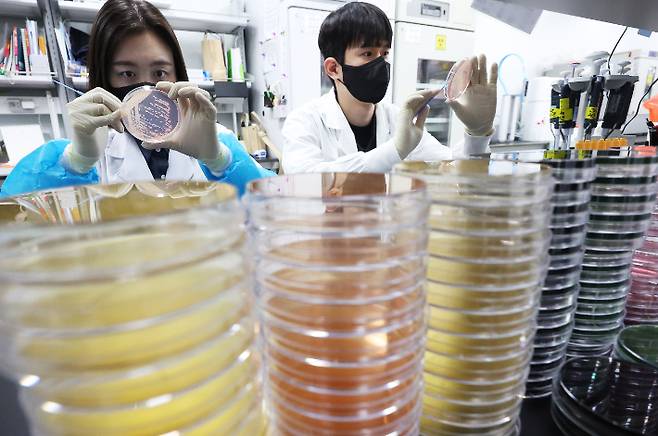
기온이 오르며 식중독 위험이 증가하고 있는 지난 19일 경기도 수원시 권선구 경기도보건환경연구원에서 연구원들이 식중독균 배양분리작업을 시연하고 있다. 연합뉴스

전주 초등학교 식중독 의심 80명 넘어, 인체서 노로바이러스
전체 맥락을 이해하기 위해서는 본문 보기를 권장합니다.
최근 집단 식중독 의심 증세를 보인 전북 전주시 한 초등학교에서 80명이 넘는 환자가 발생한 것으로 나타났다.
22일 전북특별자치도교육청에 따르면 전주시 완산구 A초등학교 식중독 의심 환자는 현재까지 83명이다.
대부분 학생이며 전북보건환경연구원이 인체 및 환경검체에 대한 가검물 조사를 한 결과 일부 인체 검체에서 노로바이러스가 검출됐다.
지난 16일 처음 식중독 의심 환자가 나왔을 때 이날 점심부터 급식을 중단했던 A초는 22일부터 급식을 재개했다.
이 글자크기로 변경됩니다.
(예시) 가장 빠른 뉴스가 있고 다양한 정보, 쌍방향 소통이 숨쉬는 다음뉴스를 만나보세요. 다음뉴스는 국내외 주요이슈와 실시간 속보, 문화생활 및 다양한 분야의 뉴스를 입체적으로 전달하고 있습니다.
22일부터 해당 초교 급식 재개
최근 집단 식중독 의심 증세를 보인 전북 전주시 한 초등학교에서 80명이 넘는 환자가 발생한 것으로 나타났다. 일부 환자 가운데 노로바이러스 감염 반응이 확인됐다.
22일 전북특별자치도교육청에 따르면 전주시 완산구 A초등학교 식중독 의심 환자는 현재까지 83명이다.
대부분 학생이며 전북보건환경연구원이 인체 및 환경검체에 대한 가검물 조사를 한 결과 일부 인체 검체에서 노로바이러스가 검출됐다. 노로바이러스는 급성 위장염을 유발하는 전염성 바이러스로 감염 후 평균 24시간 잠복기를 거쳐 증상이 나타난다.
앞서 당국은 A초의 유증상자와 급식 관계자 등 인체 검체 49건, 보존식과 조리도구·정수기 등 환경 검체 28건에 대해 검사를 맡겼다. 당국의 역학조사 결과는 약 한 달 뒤에 나올 예정이다.
지난 16일 처음 식중독 의심 환자가 나왔을 때 이날 점심부터 급식을 중단했던 A초는 22일부터 급식을 재개했다. 유증상자의 90% 이상이 완치됐고 위생 점검 등을 마쳐서다.
전북교육청은 추가 환자 발생 및 유증상자 건강상태 등을 확인하고 있다. 또한 식생활관 위생 관리와 조리실무사 위생 교육에 나섰다. 이런 식중독 발생 사례를 알리고 위생관리 강화에 대한 일선 학교의 주의도 촉구할 계획이다.
- 이메일 :jebo@cbs.co.kr
- 카카오톡 :@노컷뉴스
- 사이트 :https://url.kr/b71afn
전북CBS 최명국 기자 psy140722@cbs.co.kr
진실엔 컷이 없다
Copyright © 노컷뉴스. 무단전재 및 재배포 금지.
- 영화관으로 향한 尹, 그 속내는?…"부정선거론 끊임없이 제기할 것"[오목조목]
- 이준석, 함익병 지귀연 옹호 '50대男 룸살롱' 발언에 난처…"다신 그런 일 없도록"[노컷브이]
- '고현정 사망설' 접한 고현정 "진짜 그런 게…쇼크다"
- "네모 안에 도장을 찍어"…대선 D-12, 나만의 투표 인증 용지 찾아라[오목조목]
- 제주서 중학교 교사 숨진 채 발견…"학생가족과 갈등 겪어"
- 이준석, '단일화 피로감'…"선거까지 모든 전화 수신차단"
- 김문수, 의협 찾아 '의대증원' 사과…"尹정부 책임"
- '손흥민 협박' 남녀 검찰에 구속 송치…체포 8일 만
- 서울지하철1~8호선·의정부경전철 안전관리 최저등급
- [인천 주요 뉴스]인천시 '국비 확보 전담 책임관 제도' 운영